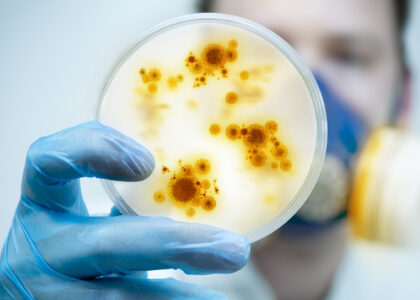
Microbial Gene Editing Services Market
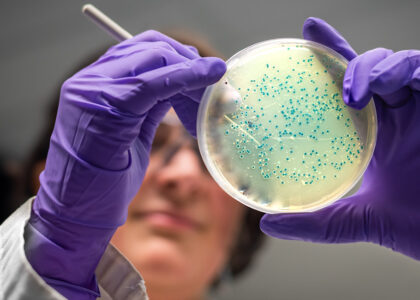
Microbial Gene Editing Services Market

Global Microbial Gene Editing Services Market: Projected to Reach USD 30.5 Billion by 2032
The global microbial gene editing services market is on the brink of unprecedented growth, poised

The global microbial gene editing services market is on the brink of unprecedented growth, poised
The global microbial gene editing services market is on the brink of unprecedented growth, poised
The global microbial gene editing services market is poised for exponential growth, projected to reach
The global microbial gene editing services market demand is projected to be worth US$ 5.35
Demand for microbial gene editing services market is projected to be worth US$ 5.35 billion
Demand for microbial gene editing services market is projected to be worth US$ 5.35 billion